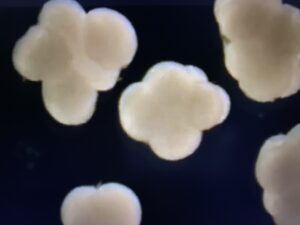

ฟลาวเวอร์การ์เด้นแบงค์ปลุกเหล่าปะการังในเดือน 7 คืนพระจันทร์เต็มดวง
โดย สำนักข่าว Thailand Today’s in news 🦅🦅

การสืบพันธุ์ของปะการังจะเกิดขึ้นเพียง 2 ช่วงในปลายฤดูร้อนตามแผนที่ของจิมการ์ดเนอร์ของหน่วยสหรัฐฯ
แนวปะการังเป็นสัตว์อาศัยในแหล่งชุมนุมสิ่งมีชีวิตขนาดจิ๋วที่เรียกว่าโพลิปซึ่งอาศัยอยู่รวมกันเป็นโคโลนี
ยกตัวอย่างปะการังสมองจะมีสองเพศในตัวเดียวกันมันจะปล่อยสเปิร์มและไข่พร้อมกัน
ทุกสายพันธุ์จะมีช่วงเวลาของตัวมันเองเพราะว่าการสืบพันธุ์ไม่ว่าจะเร็วหรือช้าเกินไปจะเสี่ยงทำให้เกิดทายาทเป็นหมัน ไม่ว่าจะอะไรจะเกิดขึ้นก็ตามปะการังทุกชนิดจะรู้จักจังหวะของตัวเองและสามารถชะลอการสืบพันธ์ุได้นานถึง 1 เดือน หากว่าสภาพอากาศนั้นเลวร้ายหรือหนาวเย็นเกินไปจะทำให้ปะการังไม่สามารถผสมพันธุ์กันได้
ตามปกติปะการังจะสืบพันธุ์ในช่วงเดือนที่ 7 คืนที่ 11 ในวันพระจันทร์เต็มดวงในช่วงเดือนสิงหาคม ซึ่งควรจะเป็นคืนที่น้ำสงบนิ่งและอบอุ่นที่สุดของปี
ทะเลที่นิ่งสงบจะช่วยให้สเปิร์มและไข่ของปะการังลอยไปพร้อมกัน โดยที่น้ำอุ่นช่วยยืดชีวิตของพวกมันไว้
โดยลมอ่อน ๆ ในคืนวันที่ 8 หลังจากพระจันทร์เต็มดวง จะเป็นคืนแรกของการรอคอยการสืบพันธุ์มาแล้ว 1 คืน โดยมียานดำน้ำควบคุมความลึกระยะไกลเรียกว่ายาน ROV โดยบันทึกการสืบพันธุ์ในระดับลึก โดยเป็นส่วนหนึ่งของกรณีศึกษาที่ ดร. ปีเตอร์ไวท์ มหาวิทยาลัยเท็กซัส ได้ทำการศึกษาวิจัยและถ่ายทำแนวประการังในครั้งนี้
นักวิทยาศาสตร์พยายามจะเข้าใจถึงจังหวะของการผสมพันธุ์ของสเปิมและไข่ของปะการัง
ตัวอย่างการเก็บหัวประการังจากเพศเมียโดยตรง ไข่ประการังมีแนวโน้มว่ายังไม่สุก เซลล์ไข่อาจมีการแตกตัวโดยที่พวกมันอาจจะผสมกับสเปิร์มของปะการังเพศเมีย ส่วนบางตัวที่แตกตัวแล้วหมายถึงว่าสเปิร์มจากโคโลนีของเพศผู้ได้มาถึงโคโลนีของเพศเมียแล้ว และที่สำคัญกว่านั้นพวกมันแตกตัวแล้วหลังจากถูกเก็บมาได้ไม่นาน อาจจะเป็นไปได้ว่าสเปิร์มอาจจะไปถึงหลังจากเพศเมียปล่อยไข่ออกมา ทำให้ไข่นั้นสุกอยู่ภายใน ทั้งที่ส่วนใหญ่ไข่จะสุกภายนอก
น้ำอันดำมืดอุดมไปด้วยชีวิตราวกับสวรรค์ถล่ม โดย.ซีเวียนักวิทยาศาสตร์ ชาวสหรัฐฯ กล่าวว่านักวิทยาศาสตร์ที่ตื่นตัวกับแนวประการังฟลาว์เวอร์แบงค์กำลังเริ่มจะค้นพบข้อมูลใหม่ ๆ ที่ล้ำค่า ไม่ใช่เพียงแค่สำหรับสิ่งที่กำลังเกิดขึ้นที่นี่ แต่มันสามารถที่จะนำมาวิเคราะห์เพื่อสร้างความเข้าใจถึงการผสมพันธุ์ร่วมกัน ขณะที่สถานอนุรักษ์สิ่งมีชีวิตจะเกิดขึ้นของแนวปะการังและมหาสมุทรทุกแห่งทั่วโลกได้อีกด้วย
ในโลกของสัตว์ใต้ท้องทะเลที่ใกล้จะสูญพันธุ์ สถานอนุรักษ์ชีวิตสัตว์ทางทะเลฟลาวเวอร์การ์เด้นแบงค์กลับเป็นข้อยกเว้นที่น่าปลื้มใจ มันเป็นสถานที่แห่งความรื่นรมย์และเกิดขึ้นครั้งแล้วครั้งเล่าเช่นที่ผ่านมานับล้านปี
การสืบพันธุ์ของปะการังจะเกิดขึ้นเพียง 2 ช่วงในปลายฤดูร้อนตามแผนที่ของจิมการ์ดเนอร์ของหน่วยสหรัฐฯ
แนวปะการังเป็นสัตว์อาศัยในแหล่งชุมนุมสิ่งมีชีวิตขนาดจิ๋วที่เรียกว่าโพลิปซึ่งอาศัยอยู่รวมกันเป็นโคโลนี
ยกตัวอย่างปะการังสมองจะมีสองเพศในตัวเดียวกันมันจะปล่อยสเปิร์มและไข่พร้อมกัน
ทุกสายพันธุ์จะมีช่วงเวลาของตัวมันเองเพราะว่าการสืบพันธุ์ไม่ว่าจะเร็วหรือช้าเกินไปจะเสี่ยงทำให้เกิดทายาทเป็นหมัน ไม่ว่าจะอะไรจะเกิดขึ้นก็ตามปะการังทุกชนิดจะรู้จักจังหวะของตัวเองและสามารถชะลอการสืบพันธ์ุได้นานถึง 1 เดือน หากว่าสภาพอากาศนั้นเลวร้ายหรือหนาวเย็นเกินไปจะทำให้ปะการังไม่สามารถผสมพันธุ์กันได้
ตามปกติปะการังจะสืบพันธุ์ในช่วงเดือนที่ 7 คืนที่ 11 ในวันพระจันทร์เต็มดวงในช่วงเดือนสิงหาคม ซึ่งควรจะเป็นคืนที่น้ำสงบนิ่งและอบอุ่นที่สุดของปี
ทะเลที่นิ่งสงบจะช่วยให้สเปิร์มและไข่ของปะการังลอยไปพร้อมกัน โดยที่น้ำอุ่นช่วยยืดชีวิตของพวกมันไว้
โดยลมอ่อน ๆ ในคืนวันที่ 8 หลังจากพระจันทร์เต็มดวง จะเป็นคืนแรกของการรอคอยการสืบพันธุ์มาแล้ว 1 คืน โดยมียานดำน้ำควบคุมความลึกระยะไกลเรียกว่ายาน ROV โดยบันทึกการสืบพันธุ์ในระดับลึก โดยเป็นส่วนหนึ่งของกรณีศึกษาที่ ดร. ปีเตอร์ไวท์ มหาวิทยาลัยเท็กซัส ได้ทำการศึกษาวิจัยและถ่ายทำแนวประการังในครั้งนี้
นักวิทยาศาสตร์พยายามจะเข้าใจถึงจังหวะของการผสมพันธุ์ของสเปิมและไข่ของปะการัง
ตัวอย่างการเก็บหัวประการังจากเพศเมียโดยตรง ไข่ประการังมีแนวโน้มว่ายังไม่สุก เซลล์ไข่อาจมีการแตกตัวโดยที่พวกมันอาจจะผสมกับสเปิร์มของปะการังเพศเมีย ส่วนบางตัวที่แตกตัวแล้วหมายถึงว่าสเปิร์มจากโคโลนีของเพศผู้ได้มาถึงโคโลนีของเพศเมียแล้ว และที่สำคัญกว่านั้นพวกมันแตกตัวแล้วหลังจากถูกเก็บมาได้ไม่นาน อาจจะเป็นไปได้ว่าสเปิร์มอาจจะไปถึงหลังจากเพศเมียปล่อยไข่ออกมา ทำให้ไข่นั้นสุกอยู่ภายใน ทั้งที่ส่วนใหญ่ไข่จะสุกภายนอก
น้ำอันดำมืดอุดมไปด้วยชีวิตราวกับสวรรค์ถล่ม โดย.ซีเวียนักวิทยาศาสตร์ ชาวสหรัฐฯ กล่าวว่านักวิทยาศาสตร์ที่ตื่นตัวกับแนวประการังฟลาว์เวอร์แบงค์กำลังเริ่มจะค้นพบข้อมูลใหม่ ๆ ที่ล้ำค่า ไม่ใช่เพียงแค่สำหรับสิ่งที่กำลังเกิดขึ้นที่นี่ แต่มันสามารถที่จะนำมาวิเคราะห์เพื่อสร้างความเข้าใจถึงการผสมพันธุ์ร่วมกัน ขณะที่สถานอนุรักษ์สิ่งมีชีวิตจะเกิดขึ้นของแนวปะการังและมหาสมุทรทุกแห่งทั่วโลกได้อีกด้วย
ในโลกของสัตว์ใต้ท้องทะเลที่ใกล้จะสูญพันธุ์ สถานอนุรักษ์ชีวิตสัตว์ทางทะเลฟลาวเวอร์การ์เด้นแบงค์กลับเป็นข้อยกเว้นที่น่าปลื้มใจ มันเป็นสถานที่แห่งความรื่นรมย์และเกิดขึ้นครั้งแล้วครั้งเล่าเช่นที่ผ่านมานับล้านปี